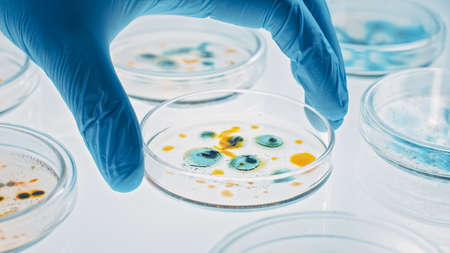
Scientist Works with Petri Dishes with Various Bacteria, Tissue and Blood Samples. Concept of Pharmaceutical Research for Antibiotics, Curing Disease with DNA Enhancing Drugs. Moving Close-up Macroの写真素材

写真素材 - Scientist Works with Petri Dishes with Various Bacteria, Tissue and Blood Samples. Concept of Pharmaceutical Research for Antibiotics, Curing Disease with DNA Enhancing Drugs. Moving Close-up Macro
作品情報
Scientist Works with Petri Dishes with Various Bacteria, Tissue and Blood Samples. Concept of Pharmaceutical Research for Antibiotics, Curing Disease with DNA Enhancing Drugs. Moving Close-up Macro
- ID:150117455
- 作品種別:写真
- 作者名:Aleksei Gorodenkov
キーワード
- antibiotics
- bacteria
- biochemistry
- biology
- biotechnology
- chemistry
- closeup
- colorful
- corona virus
- crispr
- development
- discovery
- disease
- dish
- drug
- epidemic
- experiment
- genetics
- genome
- glass
- glove
- hand
- health care
- healthcare
- industrial
- industry
- innovation
- lab
- laboratory
- macro
- medical
- medicine
- microbes
- microbiology
- microorganism
- microscopic
- molecule
- organism
- petri
- petri dish
- pharmaceutics
- research
- sample
- science
- scientist
- study
- technology
- test
- treatment
- virus
類似作品
Microbiology La...
Scientist Works...
Hands, plant sc...
Gloved hand of ...
Petri dish with...
Microbiology la...
Group of Petri ...
top view petri ...
Petri dish with...
Gloved hands of...
Gloved hands of...
laboratory drug...
Female research...
Microbiology La...
Laboratory tech...
science, chemis...
chemist wearing...
Researchers wor...
Viruses and bac...
Laboratory tech...
hand of scienti...
Growth of diffe...
Pouring liquid ...
Petri dishes wi...
Viruses and bac...
epidemic and th...
Hands of scient...
Young male chem...
Overhead view s...
Pyramids from P...
Laboratory glov...
Petri dishes wi...
Test tubes flas...
Close-up of bac...
Cosmetic swatch...
Production line...
Hands, plant sc...
Research of vir...
A skin serum or...
Research of vir...
Overhead view s...
Hand in blue gl...
Scientific hand...
Scientist Works...
Background with...
Petri dish with...
Two Petri dishe...
Microbiology la...
Researchers wor...